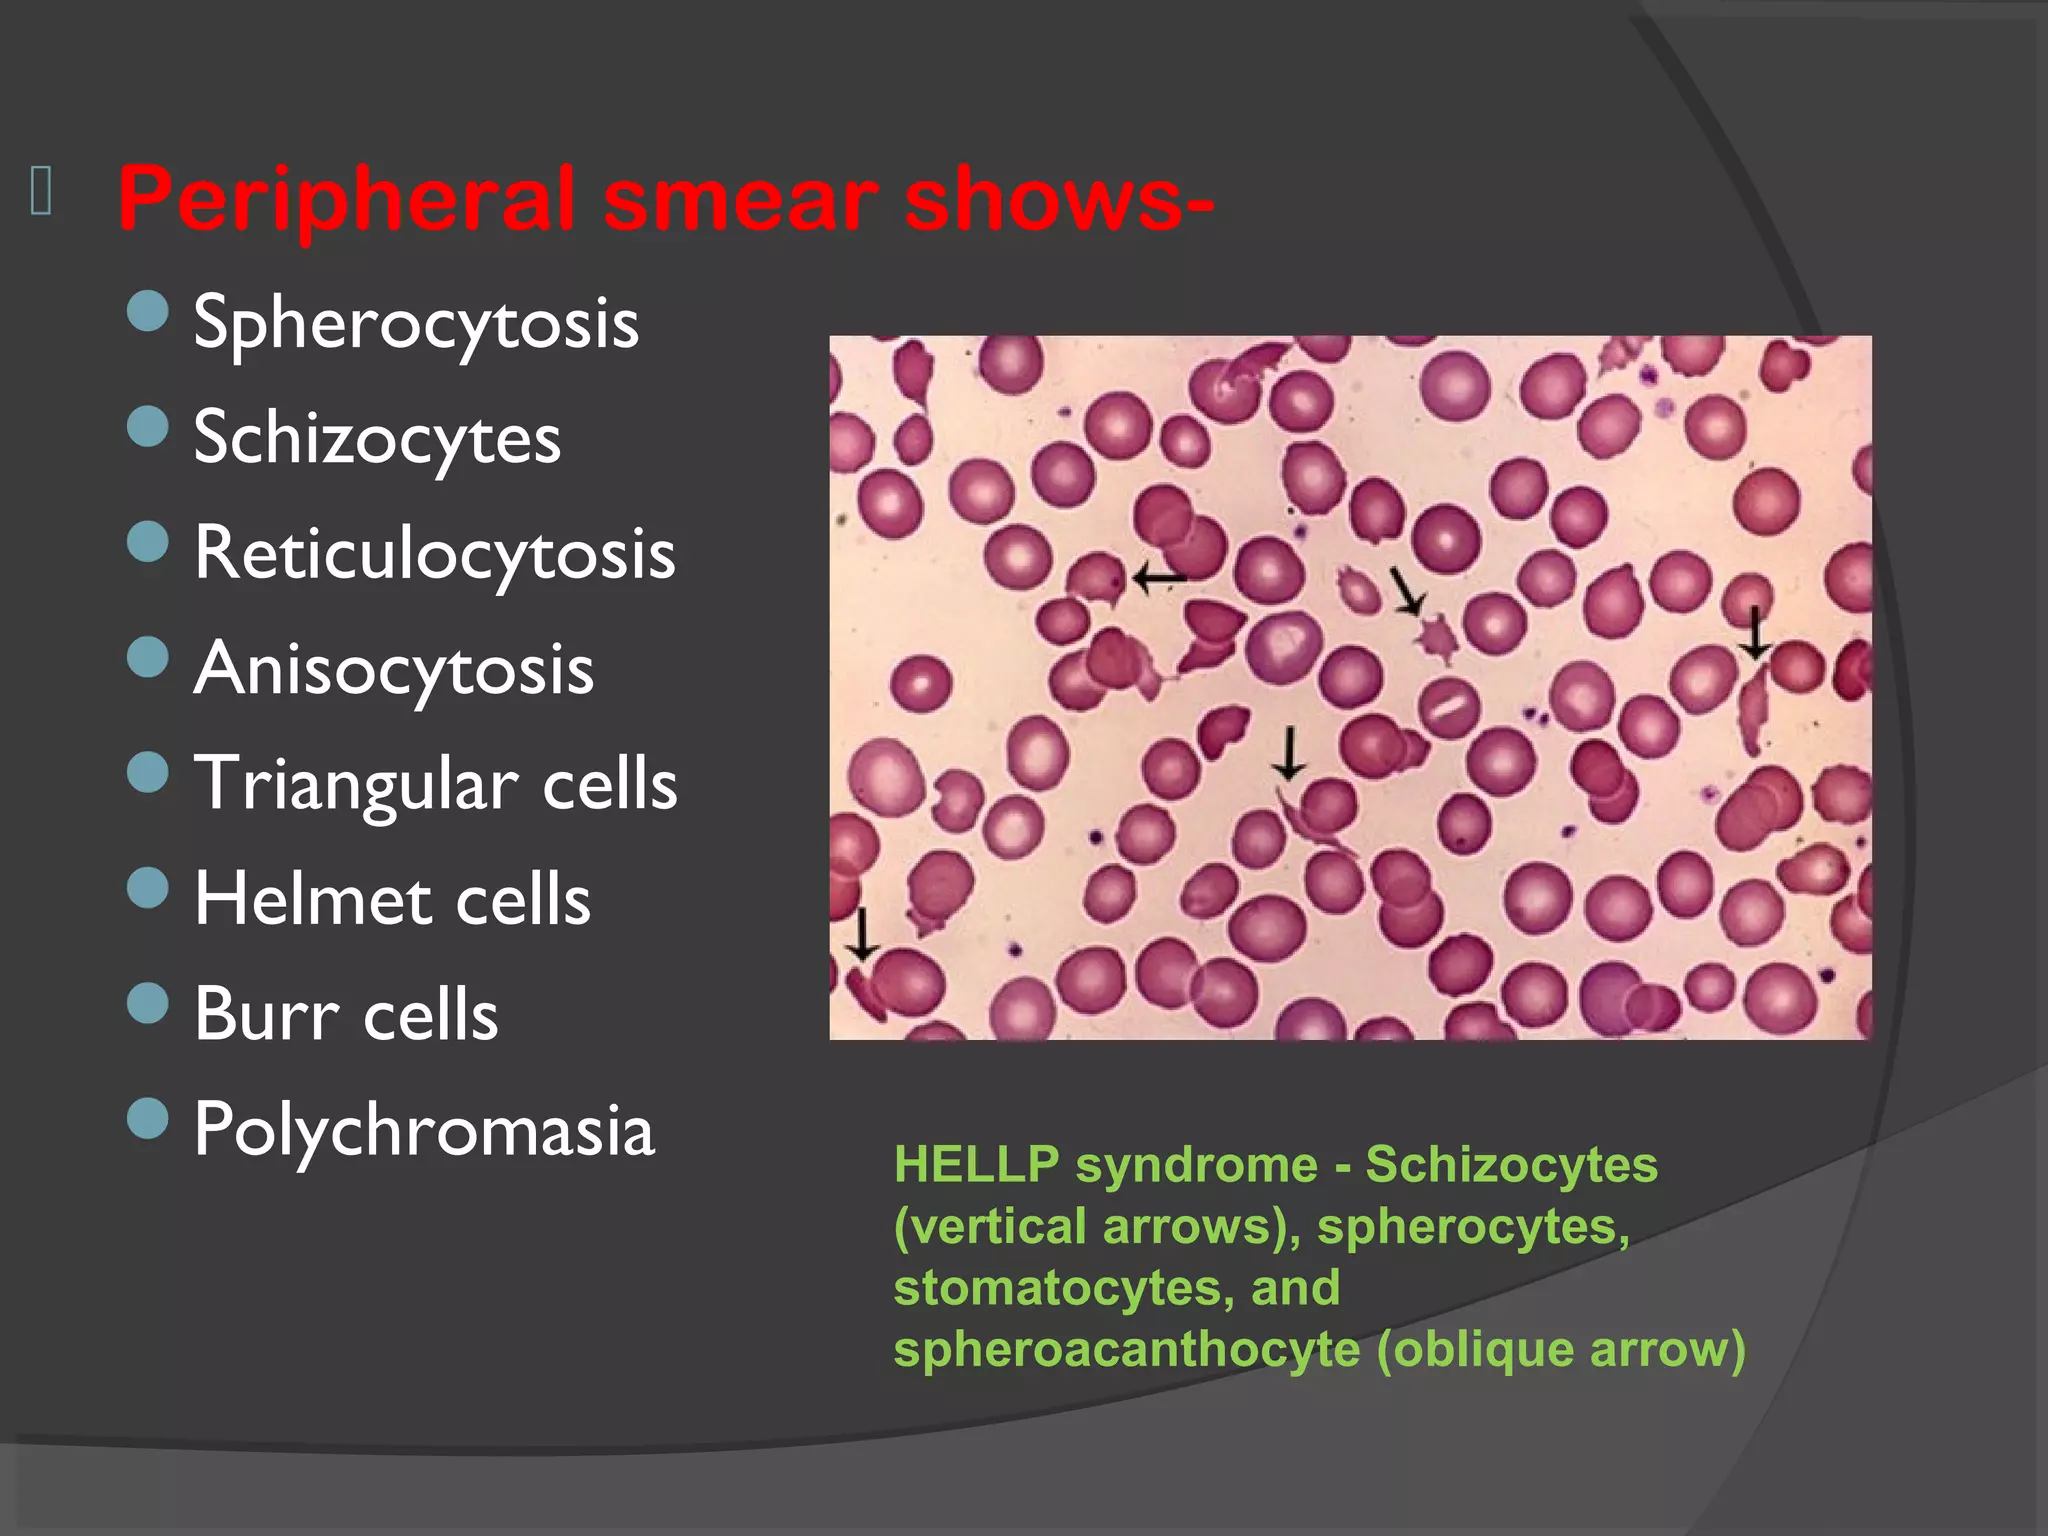
 Peripheral smear shows-
Spherocytosis
Schizocytes
Reticulocytosis
Anisocytosis
Triangular cells
Helmet cells
Burr cells
Polychromasia HELLP syndrome - Schizocytes
(vertical arrows), spherocytes,
stomatocytes, and
spheroacanthocyte (oblique arrow)

This document provides an overview of deranged coagulation profiles in obstetric patients. It begins by noting that hemorrhage remains a leading cause of maternal mortality worldwide. It then reviews the normal coagulation cascade and alterations that occur during pregnancy, including an increased potential to form thrombin due to higher coagulation factor levels. It classifies coagulation disorders in pregnancy and discusses specific conditions like von Willebrand disease, hemophilia, thrombocytopenia, HELLP syndrome, and disseminated intravascular coagulation. The document provides details on evaluating coagulation disorders and managing related conditions in obstetric patients.